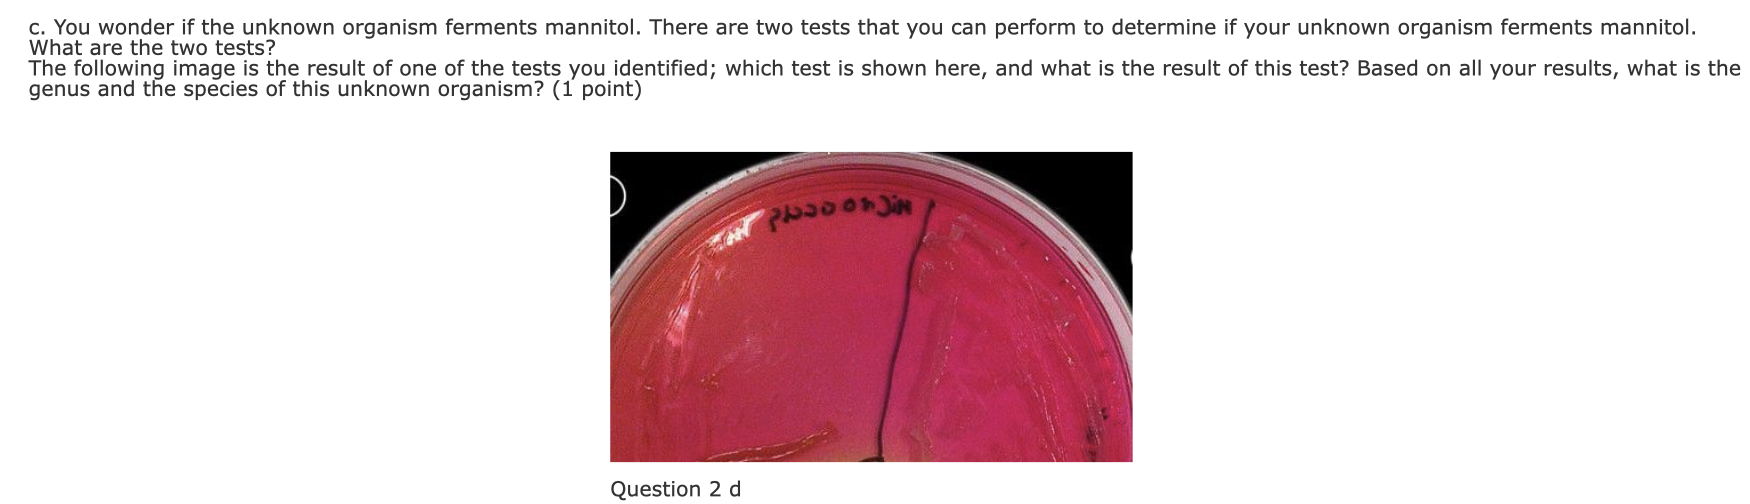
Solved x→∞c. You wonder if the unknown organism ferments | Chegg.com
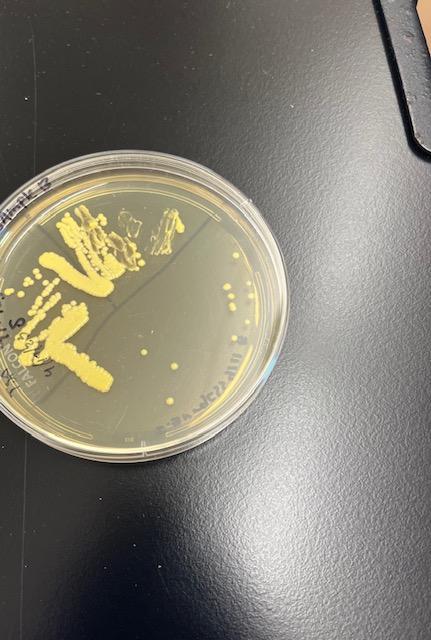
Solved What unknown organism could this be? | Chegg.com

In addition to the information above, here is a curated collection of images related to Solved N You Are Given An Unknown Organism To Identify It Chegg Com.
- Solved Identification Of Each Unknown: Based On The Results, | Chegg.Com
- Solved Possible Unknown Organisms And Expected | Chegg.Com
- Solved X→∞C. You Wonder If The Unknown Organism Ferments | Chegg.Com
- Solved Your Lab Group Is Assigned An Unknown Organism To | Chegg.Com
- Solved Identify The Unknown Micro Organisms Of Unknown A And | Chegg.Com
Find More About "Solved N You Are Given An Unknown Organism To Identify It Chegg Com"
Explore exclusive offers, detailed information, and related services about solved n you are given an unknown organism to identify it chegg com from our trusted partners.
View Special Offers